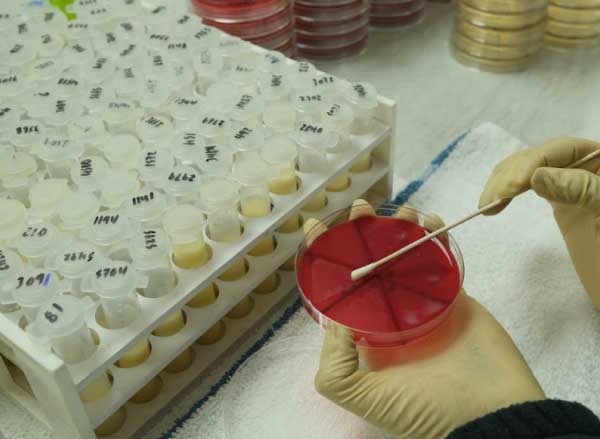

Valley
Veterinarians Inc.
Tulare County Dairy Veterinary Services
Providing exceptional veterinary services to the agricultural communities of Tulare, Kings, Kern, and Fresno Counties since 1970.
A Legacy of Unwavering Commitment to the Central Valley Dairy Community
For over 50 years, Valley Veterinarians has been the trusted partner for dairy farmers and calf ranch operators across the Central San Joaquin Valley.
Our practice was founded in 1970 by Dr. Gerald Mitchell, Dr. Bob Dickerson, and Dr. Connor Jameson with a simple mission: to provide the highest level of veterinary care to the local agricultural community.
Today, our team of 16 veterinarians and more than 10 support staff carry on that legacy, focusing primarily on the unique health needs of the dairy cattle and calves of the central valley.
Comprehensive Veterinary Solutions for Your Dairy
From advanced reproductive services to a web-based milk quality database, our team provides state-of-the-art care that has evolved with the needs of the dairy industry. We are committed to helping you increase the health, productivity, and profitability of your herd.

Advanced Reproductive Services
Expertise in services like ET/OPU/IVF and precise Reproductive Diagnostics to maximize herd fertility and genetic progress.

Integrated Herd Health Consulting
Proactive Herd Health programs, Calf Ranch Consulting, and general Dairy Consulting to maintain peak animal health and production.
Milk Quality Laboratory
Utilizing our specialized Milk Quality Laboratory to quickly identify mastitis pathogens and guide effective, targeted treatment protocols that protect your milk check.
Our Pillars of Service
Dedicated to Dairy
We specialize in providing veterinary care to dairy farms and calf ranches, ensuring our knowledge and services are perfectly aligned with your unique needs.
Longevity & Experience
With over 50 years of dedicated service to the Central Valley agricultural community, we bring unparalleled expertise and a proven track record to every herd we care for.
Strong Client Relationships
We are committed to building lasting partnerships with our clients, treating every business and family with honesty, integrity, and respect.
Ready to Partner With Us?
Contact us today to schedule a consultation and let’s get started on a healthier future for your herd.







